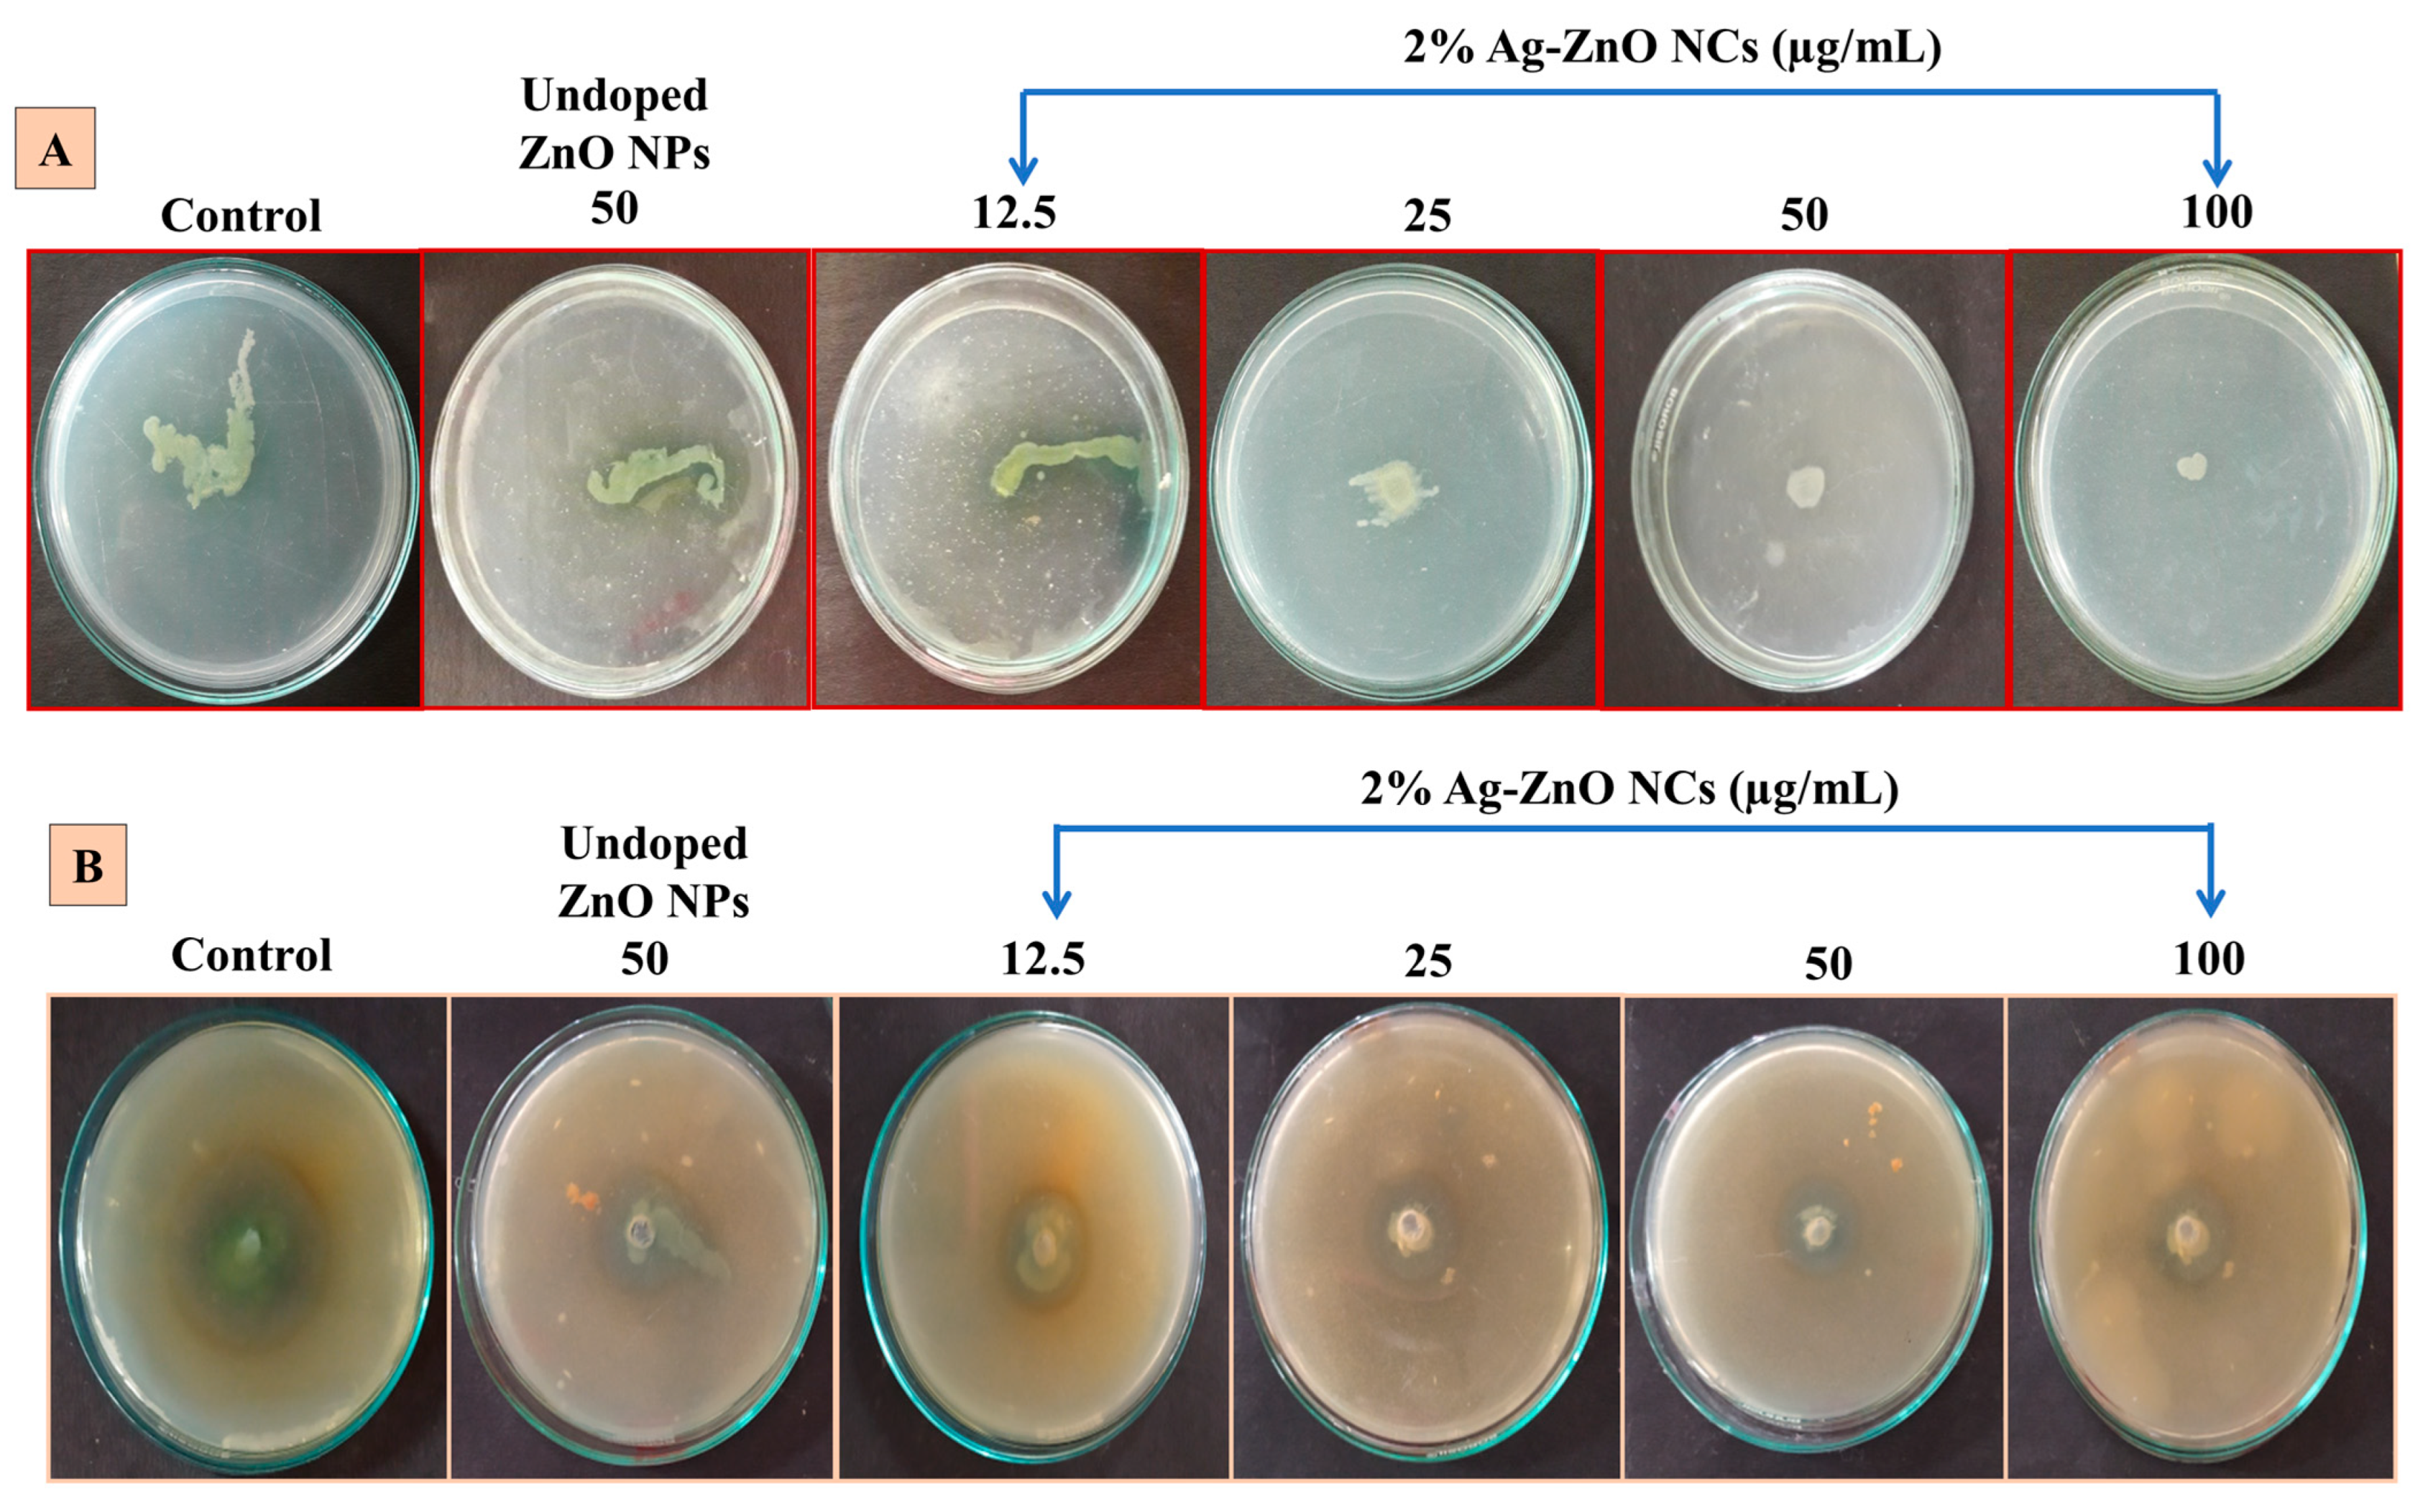
Antibiotics 14 00059 g007

Bacteria-Inspired Synthesis of Silver-Doped Zinc Oxide Nanocomposites: A Novel Synergistic Approach in Controlling Biofilm and Quorum-Sensing-Regulated Virulence Factors in Pseudomonas aeruginosa
Abstract
1. Introduction
2. Results
2.1. Isolation, Screening, and Identification of Metal-Tolerant Strains
2.2. Characterization of Pure and Ag-ZnO NCs
2.2.1. UV–Visible NIR Spectrum
2.2.2. Measuring the Size and Stability of NCs
2.2.3. XRD Analysis of Ag-ZnO NCs
2.2.4. FTIR Analysis of Ag-ZnO NCs
2.2.5. HRTEM, FESEM, and EDX Analysis of Ag-ZnO NCs
2.3. Antibiotic Susceptibility Test Against Pathogen (P. aeruginosa)
2.4. MIC and Sub-MIC Determination
2.5. Antiquorum Sensing Activity of Ag-ZnO NCs
2.5.1. Violacein Production Inhibition Assay
2.5.2. Inhibition of Pyocyanin Using Ag-ZnO NCs
2.5.3. Ag-ZnO NCs Inhibit Initial-Stage Biofilms
2.5.4. EPS Reduction and Quantification Assay Using Ag-ZnO NCs
2.5.5. Ag-ZnO NCs Disrupt Swarming Motility
2.5.6. Ag-ZnO NCs Attenuate the Protease Activity
3. Discussion
4. Materials and Methods
4.1. Reagents
4.2. Microorganisms
4.3. Isolation, Identification, and Screening of Metal-Tolerant Bacteria
4.4. Bacterial-Mediated Synthesis of NCs
4.5. Characterization of ZnO NPs and Silver-Doped Zinc Oxide NCs
4.6. Antibiotic Susceptibility Test Against the Pathogenic Strain of P. aeruginosa
4.7. Minimum Inhibitory Concentration (MIC) and Sub-MIC Determination of Ag-ZnO NCs
4.8. Anti-Quorum Sensing Activity of NCs
4.8.1. Violacein Inhibition Assay
4.8.2. Swarming Assay
4.8.3. Pyocyanin Assay
4.8.4. Congo Red Agar (CRA) Assay
4.8.5. Crystal Violet Assay
4.8.6. Effect of NCS on Exopolysaccharide (EPS) Production
4.8.7. Protease Assay
4.9. Statistical Analysis
5. Conclusions
Author Contributions
Funding
Institutional Review Board Statement
Informed Consent Statement
Data Availability Statement
Acknowledgments
Conflicts of Interest
References
- Sangaonkar, G.M.; Pawar, K.D. Garcinia indica mediated biogenic synthesis of silver nanoparticles with antibacterial and antioxidant activities. Colloids Surf. B Biointerfaces 2018, 164, 210–217. [Google Scholar] [CrossRef]
- Sahay, R.; Reddy, V.J.; Ramakrishna, S. Synthesis and applications of multifunctional composite nanomaterials. Int. J. Mech. Mater. Eng. 2014, 9, 25. [Google Scholar] [CrossRef]
- Tao, D.; Wei, F. New procedure towards size-homogeneous and well-dispersed nickel oxide nanoparticles of 30 nm. Mater. Lett. 2004, 58, 3226–3228. [Google Scholar] [CrossRef]
- Ukkund, S.J.; Ashraf, M.; Udupa, A.B.; Gangadharan, M.; Pattiyeri, A.; Marigowda, Y.K.; Patil, R.; Puthiyllam, P. Synthesis and Characterization of Silver Nanoparticles from Fuzarium Oxysporum and Investigation of Their Antibacterial Activity. Mater. Today Proc. 2019, 9, 506–514. [Google Scholar] [CrossRef]
- Osman, A.I.; Zhang, Y.; Farghali, M.; Rashwan, A.K.; Eltaweil, A.S.; AbdEl Monaem, E.M.; Mohamed, I.M.A.; Badr, M.M.; Ihara, I.; Rooney, D.W.; et al. Synthesis of green nanoparticles for energy, biomedical, environmental, agricultural, and food applications: A review. Environ. Chem. Lett. 2024, 22, 841–887. [Google Scholar] [CrossRef]
- Anandaradje, A.; Vadivel, M.; Kumar, I.; Sakthivel, N. Microbial Synthesis of Silver Nanoparticles and Their Biological Potential. In Nanoparticles in Medicine; Springer: Singapore, 2020; pp. 99–133. [Google Scholar]
- Korbekandi, H.; Iravani, S.; Abbasi, S. Optimization of biological synthesis of silver nanoparticles using Lactobacillus casei subsp. casei. J. Chem. Technol. Biotechnol. 2012, 87, 932–937. [Google Scholar] [CrossRef]
- Jayabalan, J.; Mani, G.; Krishnan, N.; Pernabas, J.; Devadoss, J.M.; Jang, H.T. Green biogenic synthesis of zinc oxide nanoparticles using Pseudomonas putida culture and its In vitro antibacterial and anti-biofilm activity. Biocatal. Agric. Biotechnol. 2019, 21, 101327. [Google Scholar] [CrossRef]
- Debnath, G.; Das, P.; Saha, A.K. Green Synthesis of Silver Nanoparticles Using Mushroom Extract of Pleurotus giganteus: Characterization, Antimicrobial, and α-Amylase Inhibitory Activity. Bionanoscience 2019, 9, 611–619. [Google Scholar] [CrossRef]
- van Spijk, J.N.; Schmitt, S.; Schoster, A. Infections caused by multidrug-resistant bacteria in an equine hospital (2012–2015). Equine Vet. Educ. 2019, 31, 653–658. [Google Scholar] [CrossRef]
- Singh, D.; Rathod, V.; Ninganagouda, S.; Herimath, J.; Kulkarni, P. Biosynthesis of silver nanoparticle by endophytic fungi Penicillium sp. Isolated from Curcuma longa (turmeric) and its antibacterial activity against pathogenic gram-negative bacteria. J. Pharm. Res. 2013, 7, 448–453. [Google Scholar] [CrossRef]
- Gudikandula, K.; Vadapally, P.; Singara Charya, M.A. Biogenic synthesis of silver nanoparticles from white rot fungi: Their characterization and antibacterial studies. OpenNano 2017, 2, 64–78. [Google Scholar] [CrossRef]
- Hamza, E.H.; El-Shawadfy, A.M.; Allam, A.A.; Hassanein, W.A. Study on pyoverdine and biofilm production with detection of LasR gene in MDR Pseudomonas aeruginosa. Saudi J. Biol. Sci. 2023, 30, 103492. [Google Scholar] [CrossRef] [PubMed]
- Bindu, S.; Man Hwan, O.; Chul Hee, C. Quorum sensing in Acinetobacter: With special emphasis on antibiotic resistance, biofilm formation and quorum quenching. AIMS Microbiol. 2016, 2, 27–41. [Google Scholar] [CrossRef]
- Hu, C.; He, G.; Yang, Y.; Wang, N.; Zhang, Y.; Su, Y.; Zhao, F.; Wu, J.; Wang, L.; Lin, Y.; et al. Nanomaterials Regulate Bacterial Quorum Sensing: Applications, Mechanisms, and Optimization Strategies. Adv. Sci. 2024, 11, 2306070. [Google Scholar] [CrossRef] [PubMed]
- Hayat, S.; Muzammil, S.; Shabana; Aslam, B.; Siddique, M.H.; Saqalein, M.; Nisar, M.A. Quorum Quenching: Role of Nanoparticles as Signal Jammers in Gram-Negative Bacteria. Future Microbiol. 2019, 14, 61–72. [Google Scholar] [CrossRef] [PubMed]
- Saleh, M.M.; Refat, A.S.; Latif, H.K.A.; Abbas, H.A.; Askoura, M. Zinc oxide nanoparticles inhibits quorum sensing and virulence in Pseudomonas aeruginosa. Afr. Health Sci. 2019, 19, 2043–2055. [Google Scholar] [CrossRef]
- Liu, L.; Li, J.-H.; Zi, S.-F.; Liu, F.-R.; Deng, C.; Ao, X.; Zhang, P. AgNPs combined with quorum sensing inhibitor increased the antibiofilm effect on Pseudomonas aeruginosa. Appl. Microbiol. Biotechnol. 2019, 103, 6195–6204. [Google Scholar] [CrossRef]
- Pang, Z.; Raudonis, R.; Glick, B.R.; Lin, T.J.; Cheng, Z. Antibiotic resistance in Pseudomonas aeruginosa: Mechanisms and alternative therapeutic strategies. Biotechnol. Adv. 2019, 37, 177–192. [Google Scholar] [CrossRef] [PubMed]
- Anusha, P.; Natarajan, D. Bioremediation potency of multi metal tolerant native bacteria Bacillus cereus isolated from bauxite mines, kolli hills, Tamilnadu-A lab to land approach. Biocatal. Agric. Biotechnol. 2020, 25, 101581. [Google Scholar] [CrossRef]
- Gnaim, R.; Polikovsky, M.; Unis, R.; Sheviryov, J.; Gozin, M.; Golberg, A. Marine bacteria associated with the green seaweed Ulva sp. for the production of polyhydroxyalkanoates. Bioresour. Technol. 2021, 328, 124815. [Google Scholar] [CrossRef] [PubMed]
- Sharma, N.; Sahay, P.P. Solution combustion synthesis of Dy-doped ZnO nanoparticles: An investigation of their structural, optical and photoluminescence characteristics. J. Lumin. 2023, 257, 119655. [Google Scholar] [CrossRef]
- Kalpana, V.N.; Kataru, B.A.S.; Sravani, N.; Vigneshwari, T.; Panneerselvam, A.; Devi Rajeswari, V. Biosynthesis of zinc oxide nanoparticles using culture filtrates of Aspergillus niger: Antimicrobial textiles and dye degradation studies. OpenNano 2018, 3, 48–55. [Google Scholar] [CrossRef]
- Yadav, L.S.R.; Pratibha, S.; Manjunath, K.; Shivanna, M.; Ramakrishnappa, T.; Dhananjaya, N.; Nagaraju, G. Green synthesis of Ag ZnO nanoparticles: Structural analysis, hydrogen generation, formylation and biodiesel applications. J. Sci. Adv. Mater. Devices 2019, 4, 425–431. [Google Scholar] [CrossRef]
- Ramesh, M.; Anbuvannan, M.; Viruthagiri, G. Green synthesis of ZnO nanoparticles using Solanum nigrum leaf extract and their antibacterial activity. Spectrochim. Acta A Mol. Biomol. Spectrosc. 2015, 136 Pt B, 864–870. [Google Scholar] [CrossRef]
- Singh, R.; Barman, P.B.; Sharma, D. Synthesis, structural and optical properties of Ag doped ZnO nanoparticles with enhanced photocatalytic properties by photo degradation of organic dyes. J. Mater. Sci. Mater. Electron. 2017, 28, 5705–5717. [Google Scholar] [CrossRef]
- Noukelag, S.K.; Razanamahandry, L.C.; Ntwampe, S.K.O.; Arendse, C.J.; Maaza, M. Industrial dye removal using bio-synthesized Ag-doped ZnO nanoparticles. Environ. Nanotechnol. Monit. Manag. 2021, 16, 100463. [Google Scholar] [CrossRef]
- Chitradevi, T.; Jestin Lenus, A.; Victor Jaya, N. Structure, morphology and luminescence properties of sol-gel method synthesized pure and Ag-doped ZnO nanoparticles. Mater. Res. Express. 2020, 7, 015011. [Google Scholar] [CrossRef]
- Kumar, K.K.P.; Dinesh, N.D.; Murari, S.K. Microwave assisted green synthesis of ZnO and Ag doped ZnO nanoparticles as antifungal and antibacterial agents using Colocasia esculenta leaf extract. Int. J. Nanoparticles 2019, 11, 239–263. [Google Scholar] [CrossRef]
- Sharma, N.; Kumar, J.; Thakur, S.; Sharma, S.; Shrivastava, V. Antibacterial study of silver doped zinc oxide nanoparticles against Staphylococcus aureus and Bacillus subtilis. Drug Invent. Today 2013, 5, 50–54. [Google Scholar] [CrossRef]
- Kumaresan, S.; Vallalperuman, K.; Sathishkumar, S. A Novel one-step synthesis of Ag-doped ZnO nanoparticles for high performance photo-catalytic applications. J. Mater. Sci. Mater. Electron. 2017, 28, 5872–5879. [Google Scholar] [CrossRef]
- Baliah, N.T.; Muthulakshmi, P.; Priyatharsini, S.L. Synthesis and Characterization of Onion Mediated Silver Doped Zinc Oxide Nanoparticles. Int. J. Sci. Res. Sci. Eng. Technol. 2018, 4, 111–120. [Google Scholar] [CrossRef]
- Babu, A.T.; Antony, R. Green synthesis of silver doped nano metal oxides of zinc & copper for antibacterial properties, adsorption, catalytic hydrogenation & photodegradation of aromatics. J. Environ. Chem. Eng. 2019, 7, 102840. [Google Scholar] [CrossRef]
- Arunkumar, M.; Farjeen, M.S.; Divya, S.K.; Jeyadoss, T. Antiquorum-Sensing and Antibacterial Activity of Green Synthesized Silver Nanoparticles against Methicillin-Resistant Staphylococcus aureus (MRSA). In Challenges and Advances in Pharmaceutical Research Vol. 1; B P International: London, UK, 2022; pp. 24–33. [Google Scholar]
- Prasad, A.R.; Rugmini Ammal, P.; Joseph, A. Effective photocatalytic removal of different dye stuffs using green synthesized zinc oxide nanogranules. Mater. Res. Bull. 2018, 102, 116–121. [Google Scholar] [CrossRef]
- Ameen, F.; AlYahya, S.; Govarthanan, M.; Aljahdali, N.; Al-Enazi, N.; Alsamhary, K.; Alshehri, W.A.; Alwakeel, S.S.; Alharbi, S.A. Soil bacteria Cupriavidus sp. Mediates the extracellular synthesis of antibacterial silver nanoparticles. J. Mol. Struct. 2020, 1202, 127233. [Google Scholar] [CrossRef]
- DeFrancesco, M.A.; Ravizzola, G.; Peroni, L.; Bonfanti, C.; Manca, N. Prevalence of multidrug-resistant Acinetobacter baumannii and Pseudomonas aeruginosa in an Italian hospital. J. Infect. Public Health 2013, 6, 179–185. [Google Scholar] [CrossRef] [PubMed]
- Khan, F.; Lee, J.-W.; Manivasagan, P.; Pham, D.T.N.; Oh, J.; Kim, Y.-M. Synthesis and characterization of chitosan oligosaccharide-capped gold nanoparticles as an effective antibiofilm drug against the Pseudomonas aeruginosa PAO1. Microb. Pathog. 2019, 135, 103623. [Google Scholar] [CrossRef] [PubMed]
- Koh, K.H.; Tham, F.Y. Screening of traditional Chinese medicinal plants for quorum-sensing inhibitors activity. J. Microbiol. Immunol. Infect. 2011, 44, 144–148. [Google Scholar] [CrossRef] [PubMed]
- Singh, B.R.; Singh, B.N.; Singh, A.; Khan, W.; Naqvi, A.H.; Singh, H.B. Mycofabricated biosilver nanoparticles interrupt Pseudomonas aeruginosa quorum sensing systems. Sci. Rep. 2015, 5, 13719. [Google Scholar] [CrossRef]
- Mudaliar, S.B.; Bharath Prasad, A.S. A biomedical perspective of pyocyanin from Pseudomonas aeruginosa: Its applications and challenges. World J. Microbiol. Biotechnol. 2024, 40, 90. [Google Scholar] [CrossRef]
- Tabassum, N.; Khan, F.; Jeong, G.-J.; Jo, D.-M.; Kim, Y.-M. Silver nanoparticles synthesized from Pseudomonas aeruginosa pyoverdine: Antibiofilm and antivirulence agents. Biofilm 2024, 7, 100192. [Google Scholar] [CrossRef]
- Pham, D.T.N.; Khan, F.; Phan, T.T.V.; Park, S.K.; Manivasagan, P.; Oh, J.; Kim, Y.M. Biofilm inhibition, modulation of virulence and motility properties by FeOOH nanoparticle in Pseudomonas aeruginosa. Braz. J. Microbiol. 2019, 50, 791–805. [Google Scholar] [CrossRef]
- Tabassum, N.; Jeong, G.-J.; Jo, D.-M.; Khan, F.; Kim, Y.-M. Attenuation of biofilm and virulence factors of Pseudomonas aeruginosa by tetramethylpyrazine-gold nanoparticles. Microb. Pathog. 2024, 191, 106658. [Google Scholar] [CrossRef] [PubMed]
- Rajkumari, J.; Busi, S.; Vasu, A.; Rajasekharreddy, P. Facile green synthesis of baicalein fabricated gold nanoparticles and their antibiofilm activity against Pseudomonas aeruginosa PAO1. Microb. Pathog. 2017, 107, 261–269. [Google Scholar] [CrossRef] [PubMed]
- Mani, G.; Rajendran, I.; Jayakumar, T.; Mani, A.; Govindaraju, R.; Dhayalan, S. Evaluation of Antibiofilm and Antiquorum Sensing Activities of Fucoidan Characterized from Padina boryana against Nosocomial Pathogens. Appl. Biochem. Biotechnol. 2024, 196, 4727–4744. [Google Scholar] [CrossRef]
- Shah, S.; Gaikwad, S.; Nagar, S.; Kulshrestha, S.; Vaidya, V.; Nawani, N.; Pawar, S. Biofilm inhibition and anti-quorum sensing activity of phytosynthesized silver nanoparticles against the nosocomial pathogen Pseudomonas aeruginosa. Biofouling 2019, 35, 34–49. [Google Scholar] [CrossRef] [PubMed]
- Alavi, M.; Karimi, N.; Salimikia, I. phytosynthesis of zinc oxide nanoparticles and its antibacterial, antiquorum sensing, antimotility, and antioxidant capacities against multidrug resistant bacteria. J. Ind. Eng. Chem. 2019, 72, 457–473. [Google Scholar] [CrossRef]
- Abinaya, M.; Gayathri, M. Inhibition of biofilm formation, quorum sensing activity and molecular docking study of isolated 3, 5, 7-Trihydroxyflavone from Alstonia scholaris leaf against P. aeruginosa. Bioorg. Chem. 2019, 87, 291–301. [Google Scholar] [CrossRef]
- Sathiskumar, P.; Khan, F. Leveraging bacteria-inspired nanomaterials for targeted controlling biofilm and virulence properties of Pseudomonas aeruginosa. Microb. Pathog. 2024, 197, 107103. [Google Scholar] [CrossRef]
- Richa, G.; Tarun, K.; Amita, M. Isolation, identification and characterization of heavy metal resistant bacteria from soil of an iron industry, Haryana (India). Int. J. Pharm. Sci. Res. 2016, 7, 1308–1313. [Google Scholar] [CrossRef]
- Khan, M.H.; Unnikrishnan, S.; Ramalingam, K. Bactericidal potential of silver-tolerant bacteria derived silver nanoparticles against multi drug resistant ESKAPE pathogens. Biocatal. Agric. Biotechnol. 2019, 18, 100939. [Google Scholar] [CrossRef]
- Malaikozhundan, B.; Vaseeharan, B.; Vijayakumar, S.; Thangaraj, M.P. Bacillus thuringiensis coated zinc oxide nanoparticle and its biopesticidal effects on the pulse beetle, Callosobruchus maculatus. J. Photochem. Photobiol B 2017, 174, 306–314. [Google Scholar] [CrossRef] [PubMed]
- Fournier, C.; Poirel, L.; Nordmann, P. Implementation and evaluation of methods for the optimal detection of carbapenem-resistant and colistin-resistant Pseudomonas aeruginosa and Acinetobacter baumannii from stools. Diagn. Microbiol. Infect. Dis. 2020, 98, 115121. [Google Scholar] [CrossRef] [PubMed]
- Vijayakumar, K.; Ramanathan, T. Antiquorum sensing and biofilm potential of 5-Hydroxymethylfurfural against Gram positive pathogens. Microb. Pathog. 2018, 125, 48–50. [Google Scholar] [CrossRef] [PubMed]
- Ganesh, P.S.; Rai, R.V. Inhibition of quorum-sensing-controlled virulence factors of Pseudomonas aeruginosa by Murraya koenigii essentialoil: A study in a Caenorhabditis elegans infectious model. J. Med. Microbiol. 2016, 65, 1528–1535. [Google Scholar] [CrossRef]
- Rajkumari, J.; Borkotoky, S.; Murali, A.; Suchiang, K.; Mohanty, S.K.; Busi, S. Attenuation of quorum sensing controlled virulence factors and biofilm formation in Pseudomonas aeruginosa by pentacyclictriterpenes, betulin and betulini cacid. Microb. Pathog. 2018, 118, 48–60. [Google Scholar] [CrossRef] [PubMed]
- Rubini, D.; Banu, S.F.; Nisha, P.; Murugan, R.; Thamotharan, S.; Percino, M.J.; Subramani, P.; Nithyanand, P. Essential oils from unexplored aromatic plants quench biofilm formation and virulence of Methicillin resistant Staphylococcus aureus. Microb. Pathog. 2018, 122, 162–173. [Google Scholar] [CrossRef] [PubMed]
- Badr-Eldin, S.M.; Aldawsari, H.M.; Ahmed, O.A.A.; Kotta, S.; Abualsunun, W.; Eshmawi, B.A.; Khafagy, E.-S.; Elbaramawi, S.S.; Abbas, H.A.; Hegazy, W.A.H.; et al. Utilization of zein nano-based system for promoting antibiofilm and anti-virulence activities of curcumin against Pseudomonas aeruginosa. Nanotechnol. Rev. 2024, 13, 20230212. [Google Scholar] [CrossRef]

Disclaimer/Publisher’s Note: The statements, opinions and data contained in all publications are solely those of the individual author(s) and contributor(s) and not of MDPI and/or the editor(s). MDPI and/or the editor(s) disclaim responsibility for any injury to people or property resulting from any ideas, methods, instructions or products referred to in the content. |
© 2025 by the authors. Licensee MDPI, Basel, Switzerland. This article is an open access article distributed under the terms and conditions of the Creative Commons Attribution (CC BY) license (https://creativecommons.org/licenses/by/4.0/).
Share and Cite
Karthikeyan, A.; Thirugnanasambantham, M.K.; Khan, F.; Mani, A.K. Bacteria-Inspired Synthesis of Silver-Doped Zinc Oxide Nanocomposites: A Novel Synergistic Approach in Controlling Biofilm and Quorum-Sensing-Regulated Virulence Factors in Pseudomonas aeruginosa. Antibiotics 2025, 14, 59. https://doi.org/10.3390/antibiotics14010059
Karthikeyan A, Thirugnanasambantham MK, Khan F, Mani AK. Bacteria-Inspired Synthesis of Silver-Doped Zinc Oxide Nanocomposites: A Novel Synergistic Approach in Controlling Biofilm and Quorum-Sensing-Regulated Virulence Factors in Pseudomonas aeruginosa. Antibiotics. 2025; 14(1):59. https://doi.org/10.3390/antibiotics14010059
Chicago/Turabian StyleKarthikeyan, Abirami, Manoj Kumar Thirugnanasambantham, Fazlurrahman Khan, and Arun Kumar Mani. 2025. "Bacteria-Inspired Synthesis of Silver-Doped Zinc Oxide Nanocomposites: A Novel Synergistic Approach in Controlling Biofilm and Quorum-Sensing-Regulated Virulence Factors in Pseudomonas aeruginosa" Antibiotics 14, no. 1: 59. https://doi.org/10.3390/antibiotics14010059
APA StyleKarthikeyan, A., Thirugnanasambantham, M. K., Khan, F., & Mani, A. K. (2025). Bacteria-Inspired Synthesis of Silver-Doped Zinc Oxide Nanocomposites: A Novel Synergistic Approach in Controlling Biofilm and Quorum-Sensing-Regulated Virulence Factors in Pseudomonas aeruginosa. Antibiotics, 14(1), 59. https://doi.org/10.3390/antibiotics14010059

